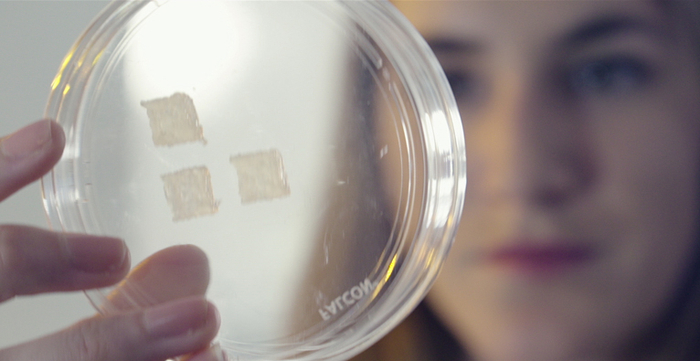

来源:21世纪经济报道

文/王睿 编辑/鄢子为 江昱玢
辽阳首富郑春颖,动作不断。
10月30日,作为伽蓝集团董事长,他前往大理,出席一个签约仪式。集团旗下品牌自然堂,联名这座旅游城市,推出“极地圣水大理限量版”。
有消息称,伽蓝集团考虑最早于明年赴港上市,至多募资5亿美元。
天眼查显示,郑春颖持有59.4%的伽蓝股份,身家不菲。
他以170亿元的财富,登上《2023年胡润全球富豪榜》,成为辽宁辽阳首富,身家甚至超过丸美股份、敷尔佳等企业的实控人。
在行业摸爬滚打20多年,财力雄厚、从不融资的他,这次似乎坐不住了。
增长疲软
“只要能够解决资金问题,(伽蓝)就可以不上市。”伽蓝集团多次回应,不会IPO。
针对此次上市传闻,伽蓝却未予否认。或许,郑春颖已觉察潜在危机,要提前储备资金。
11月1日,天猫发布“美妆行业抢先购首日品牌成绩单,自然堂排在第17位。

其老对手珀莱雅势头强劲,登顶榜首,后起之秀薇诺娜也进入前10 。
近几年的“大促”中,自然堂显露颓势。
据魔镜数据,2016-2019年,“双十一美妆品牌TOP10”榜单中,自然堂尚能占有一席,2020年后,未见其身影。

“(2023年)既要营收增长,目标增长18%,又要利润大幅度增长。”郑春颖年初立下目标。
若要完成目标,还得看核心产品的表现。
22岁的自然堂,是郑春颖卖得最好的品牌,据魔镜数据,其9月销量超52万件。
进入存量市场比拼,郑春颖加大品牌曝光。
去年下半年,自然堂先后宣布赵露思、王一博、虞书欣等三位明星代言人。此前,品牌代言不乏古力娜扎、罗云熙等明星 。郑春颖还切入大学生群体,赞助公关策划大赛。
一套组合拳之后,增长如何,静待今年双十一业绩验收。
押注线上
为提振业绩,郑春颖改革渠道。
早期,自然堂的发展主要依赖线下,经销为主、直销为辅,占据了下沉市场大片阵地。2019年,伽蓝线下份额占比达7成。
近两年,郑春颖布局小程序等线上渠道,开启直播带货,与李佳琦等头部主播合作。
《21CRR》记者来到自然堂广州岗顶专柜,销售人员当场打开伽蓝美妆云店小程序。
“能展示不同门店、链接官方福利和直播活动,以及积分兑换等。顾客使用起来比较方便。”
记者点开该小程序,切换门店时,主页的产品展示、直播内容未发生变化,与集团宣传的“千店千面”营销策略,有一定差距。

“伽蓝已实现全域数字化。”郑春颖信心十足。
4月,伽蓝集团发布的ESG报告称,2022年数字化营收占比98.8%,同比增长50.8%。
郑春颖加大科研投入,研发费用提升至营收的 4.5%左右。
其自研成分“喜马拉雅超极酵母喜默因”,成为自然堂的卖点之一。
伽蓝集团研发总经理邹岳介绍,公司先后组织40多次的喜马拉雅科考,10余次前往雪山、草地等各种极端环境中考察,采集微生物样本。
8月底,自然堂“极地精华露”,在李佳琦直播间,首发销量破万套。
一位主播介绍,这款名为“极地圣水”的精华露,亮点在于高浓度的“喜默因”原浆与其它基础成分搭配,称其为“国货里的神仙水”。
另一款含有喜默因成分的精华液产品“自然堂小紫瓶”,双十一期间仅“李佳奇直播间”相关链接,就已售超10万组。
对应269元(115ml)的到手价,光是这一单品,郑春颖就卖超2690万元。
父女联手
郑春颖出生在东北辽阳的普通工人之家,自幼成绩优异,顺利考进东北财经大学。
几年后,他辞去财政局的“铁饭碗”工作,投身美容院行业,首月盈利7万元。
2001年,郑离开沈阳,前往上海成立伽蓝集团。
“当时心里想的,是要在上海这块热土上,创造出属于中国人的一流化妆产品。”郑春颖回忆道。
创业22年,财富水涨船高,59岁的郑老板早做打算,培养女儿郑确接班。
大学毕业后,她进入时尚杂志工作,又去日本留学,当旅行、美妆博主,账号一度拥有十几万粉丝。

2019年,她回到伽蓝,打造香水品牌莎辛那。
从品牌创意、产品开发到设计,她都一一经手。一年后,莎辛那上线。3年来,其天猫旗舰店积攒了9.2万粉丝,尚未出现破万的爆款。
一番历练后,郑确坐到了伽蓝集团新锐品牌事业部总经理的位置,还得到了负责彩妆品牌COMO的机会。

郑春颖也试着推新品。
比如,婴童品牌“己出”,于7月面世,其天猫旗舰店已上架10件商品,仅有一款抗干燥面霜销量破千。
坐拥自然堂、美素、莎辛那、己出等七大品牌,父女正合力将郑家的美妆护肤帝国做得更大。
(作者:王睿 编辑:鄢子为,江昱玢)

